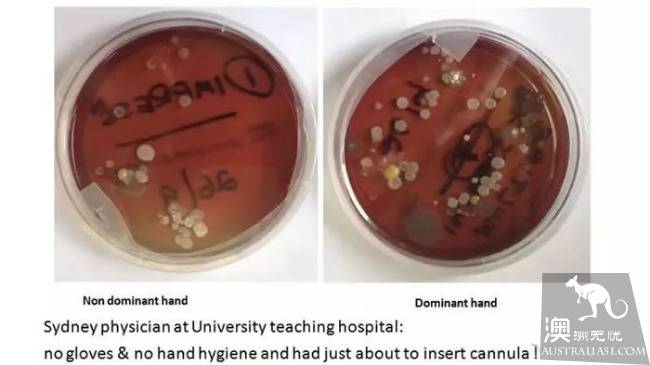

新州医生不洗手!审计人员表示毫无无奈,从业人员仍然需要教育。

最新发布的审计数据显示,新州10家重点医院的手部卫生清洁率跌破80%的基准大关。其中,该项数据最高的John Hunter Hospital医院手部清洁率高达92.5%。Manning Hospital医院的数据最低,为74.5%,Gosford Hospital医院、Royal North Shore医院和St. Vincent’s Hospital医院表现同样不佳,分别为75.4%、76.9%和79.9%。
研究表明,悉尼几家重点医院的医生护士在检查不到位时常常忽视手部清洁工作,给病人的人身安全造成很大的隐患。新南威尔士大学(UNSW)发布最新研究数据,在视察人员不在场时,医疗人员的手部清洁率从94%下降至30%。该数据让人非常忧心,手部卫生是医院控制感染的基础工作,一方面减少医生感染严重病症的可能性,另一方面,医院如果不是无污染环境,病人的死亡率会上升20-30%。因此,研究人员希望政府和医院能够出手解决手部清洁问题,比如对从业人员进行再教育,科普手部卫生的重要性。

2010年时,该项数据高达84%,但重新审视这项数据,真实性存疑。调查报告的第一作者玛丽露易·麦克劳(Mary-Louise McLaws)表示,数据统计过程中存在很多疏漏。在最新的检查中,所有数据都是由机器调查的,机器安装在水池边的洗手液挤压器中,然而之前的调查主要由人工收集数据。负责提升该数据的澳洲手部卫生项目(Hand Hygiene Australia, HHA)工作人员林赛·格雷森(Lindsay Grayson)对此项数据表示高度关注。

麦克劳和格雷森都认为改善医院环境不能完全依靠自动设备,相比起机器,对医生和护士的再教育更加重要。“临床工作人员必须改变他们的行为习惯,这才是最紧要的事,”格雷森这样评论,麦克劳也持有相似的观点,“现在临床人员并不认为手部卫生对自己和他人的安全有很大的影响。”现在HHA意识到问题的重要性,正计划着手进一步提升临床从业人员的手部清洁率。